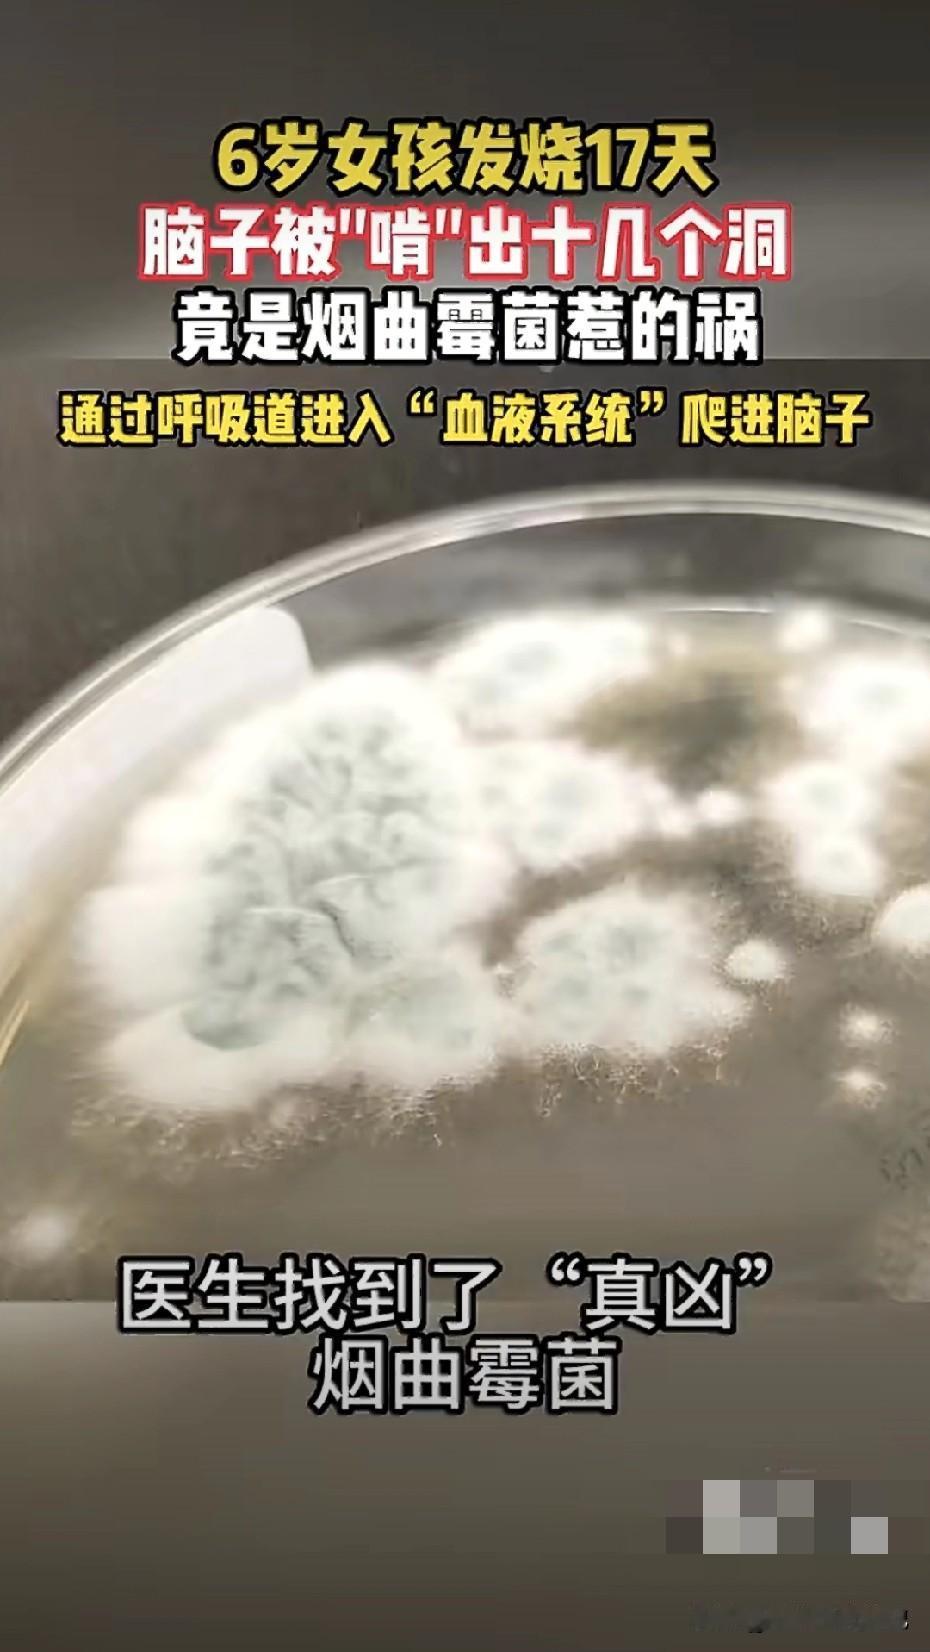

6岁娃脑子被“啃”出20个洞,竟因爸妈回了趟老家,年前大扫除,别把孩子往霉窝里带!“不就是扫个老屋嘛,能有啥事?”郑州一对爸妈万万没想到,一趟回老家大扫除,竟让6岁女儿持续高烧17天,脑子里被烟曲霉“啃”出20多个窟窿。 烟曲霉这玩意儿,肉眼看不见,却爱躲在长期不通风的墙角、衣柜背、床垫下。孢子一扬,顺着娃的呼吸道钻进血液,一路爬进大脑,见组织就“开啃”。初期只是发烧头痛,跟感冒一模一样,等娃开始抽搐、意识模糊,已经晚了。 别以为只有老房子才有,洗衣机胶圈、冰箱密封条、卫生间瓷砖缝,都是它的快乐老家。年前大扫除,最高危的是两类人:免疫系统没长全的孩子,和以为“扛一扛就好”的大人。 小编在这里给各位家长提个醒: [微风]带娃回老屋,先开门窗通风30分钟,人再进去;打扫时娃一律外放,禁止围观。 [微风]自己上阵:N95口罩+长袖+手套,湿布擦灰,拒绝干扫尘土飞扬。 [微风]看见发黑、发绿的霉斑,别心疼那面墙,直接铲掉重刷,或上专业除霉剂。 [微风]娃要是发烧超3天还头痛、呕吐、精神差,别在家瞎喂退烧药,直奔医院,说明“可能霉菌感染”,让医生少走弯路。 霉不可貌相,菌不可斗量。大扫除不是打仗,但装备得按生化危机来! 朋友们,你家老屋/旧柜子有没有闻到过一股“潮乎乎”的霉味?留言说说你最怕打扫哪个角落,或者分享你除霉的小妙招,让大伙都避避坑!(图源网络)